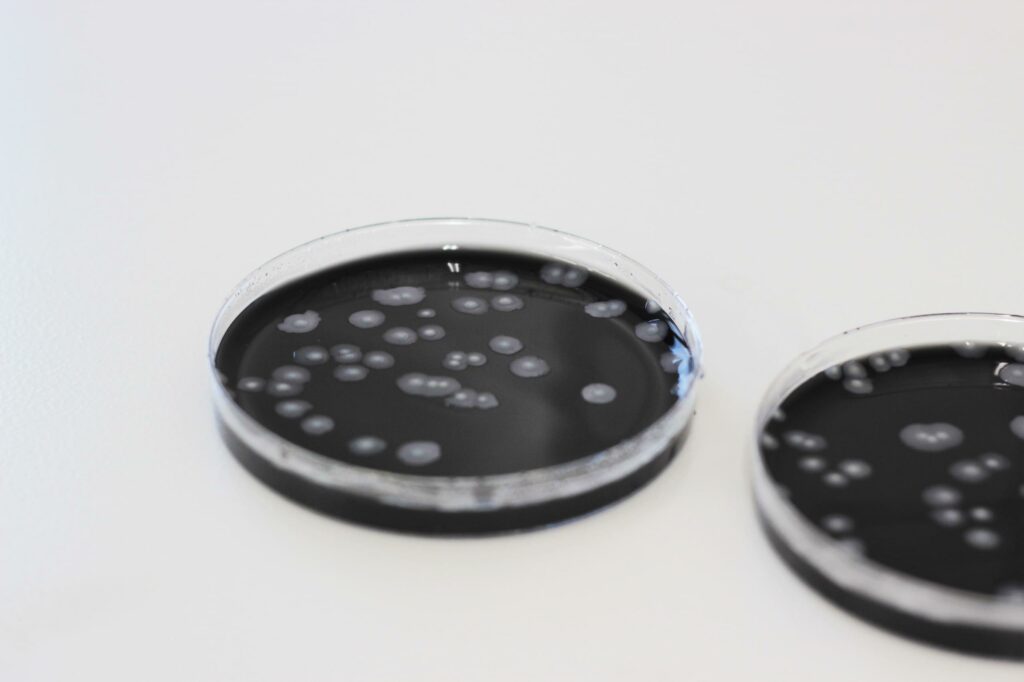
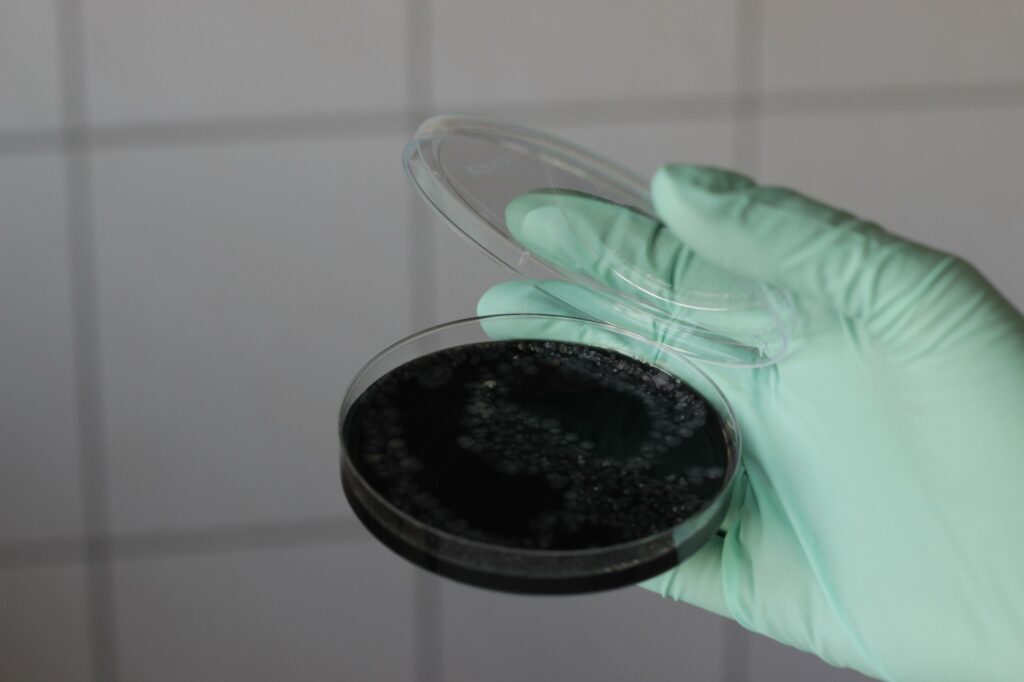

Sie sind in der Wohnungsverwaltung und Immobilienwirtschaft oder als private Vermieter tätig und müssen das Trinkwasser auf Legionellen überprüfen? Auch als Betreiber von Whirlpools, Kühltürmen und Luftbefeuchtern müssen Sie das Wasser einer Legionellenuntersuchung zu unterziehen. Auch öffentliche Einrichtungen, wie Kindergärten, Schulen, Krankenhäuser und Pflegeeinrichtungen sind verpflichtet, die Untersuchung entsprechend der Trinkwasserversorgung (TrinkwV) vorzunehmen.
Legionellen sind Bakterien, die im Trinkwasser auftreten und Krankheiten verursachen können. Sie können über Aerosole (z. B. beim Duschen) in den menschlichen Körper und somit in die Lunge gelangen. Die Folge können schwere Lungenentzündungen sein. In Warmwasserleitungen in Gebäuden finden Legionellen zwischen 25 °C und 45 °C ihre bevorzugten Wachstumsbedingungen und können sich an Ablagerungen des Rohrsystems vermehren.
Im Bereich der Probenahme sind wir regional tätig und für Kunden im Raum Sachsen sowie südliches Brandenburg und Sachsen-Anhalt unterwegs. Wir führen für Sie Legionellenprüfungen nach TrinkwV sowie Legionellen- und Abklatschuntersuchungen in Klimaanlagen und Lüftungssystemen durch.

Ansprechpartner


